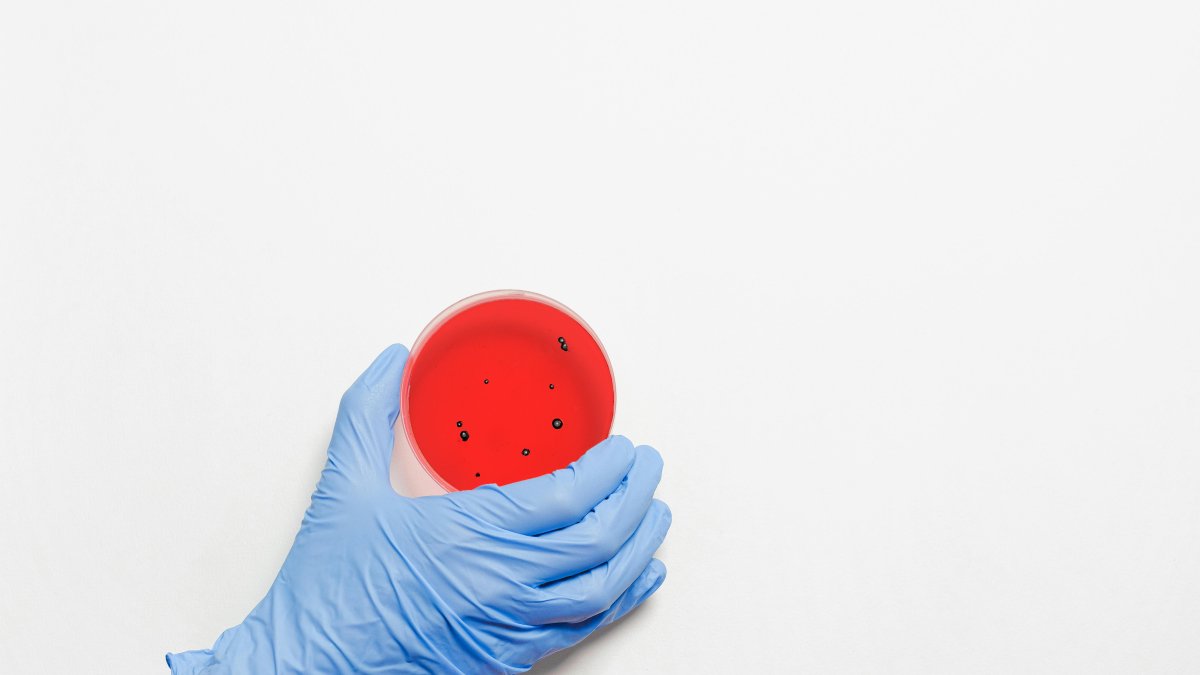
Referencial. Una evaluación de riesgos determinó que es

Organismos sanitarios piden más control tras el primer caso de mpox en Europa
El ECDC pidió vigilancia efectiva, pruebas de laboratorio, investigación epidemiológica y capacidad para rastrear contactos
Referencial. Una evaluación de riesgos determinó que es "muy probable" que haya más casos importados de mpox.
Los organismos sanitarios europeos instaron este 16 de agosto a reforzar las medidas de control tras la detección ayer en Suecia del primer caso de mpox (antes conocido como viruela del mono) fuera de África y reducir así el riesgo de una transmisión amplia.
(Sigue leyendo: Estas son las empresas relacionadas a alias Negro Tulio y el Municipio de Durán )
El Centro Europeo para la Prevención y Control de Enfermedades (ECDC) apuntó en una evaluación de riesgos actualizada que es "muy probable" que haya más casos importados de mpox, pero descartó que pueda haber un contagio continuado si se actúa con rapidez.
"La probabilidad de una transmisión sostenida en Europa es muy baja, siempre y cuando los casos importados sean diagnosticados de forma rápida y se implementen medidas de control", señaló este organismo de referencia para infecciones de la Unión Europea (UE) con sede en Estocolmo.
El ECDC pidió asegurar una vigilancia efectiva, pruebas de laboratorio, investigación epidemiológica y capacidad para rastrear contactos, iniciativas similares a las que reclama la Organización Mundial de la Salud (OMS).
"La identificación de la primera infección de mpox clado 1b en Suecia resalta la necesidad de que los países afectados afronten el virus juntos", advirtió en su cuenta en la red social X el secretario general de la OMS, Tedros Adhanom Ghebreyesus.
Tedros llamó a aplicar las "lecciones" aprendidas de anteriores emergencias para la salud pública de alcance internacional e instó a una mayor vigilancia y a "trabajar juntos para entender la transmisión" mediante el intercambio de información y herramientas como las vacunas.
(Te puede interesar: Irene Vélez crea una granja de trolls VIP para meter alharaca )
"También urjo a los gobiernos, autoridades sanitarias y a la población en general a no estigmatizar o discriminar a individuos o comunidades afectadas por el mpox", ha señalado en la misma red el director de OMS-Europa, Hans Kluge.
Kluge recordó que el brote de mpox en 2022 fue "rápidamente contrarrestado" a través de colaboraciones con las comunidades afectadas, tomando las medidas protectoras apropiadas y creando un ambiente "solidario".
Suecia no adopta medidas adicionales
Las autoridades suecas informaron ayer 15 de agosto de un caso en la región de Estocolmo, una persona que estuvo en la zona de África afectada por el brote, el primero fuera de ese continente, lo que en palabras de Kluge era "una cuestión de tiempo".
(Te invitamos a leer: Starbucks en Ecuador: Esto es lo que costará tomarse un café )
La directora general en funciones de la Agencia de Salud Pública sueca, Olivia Wigzell, explicó que el infectado ya está a tratamiento y que no se considera que el riesgo para la población sueca haya aumentado, por lo que no se han adoptado medidas de control de infecciones adicionales.
El Ministerio de Exteriores sueco comunicó hoy que no desaconseja los viajes a ningún país a causa del riesgo de contagiarse de mpox, dos días después de que la OMS declarase el actual brote en la República Democrática del Congo (CDC), que se ha extendido a países cercanos, como emergencia de salud pública de alcance internacional.
La nueva variante puede contagiarse fácilmente con un contacto estrecho entre dos individuos, sin que sea necesario un contacto sexual, y está considerada más peligrosa que la de 2022, que en su momento dio origen a otra alerta similar, levantada en mayo pasado tras contenerse su propagación y considerarse que la situación estaba bajo control.
CONTROL
Vacunas para adolescentes y niños
La farmacéutica danesa Bavarian Nordic anunció hoy que ha solicitado a la Agencia Europea de Medicamentos (EMA) que extienda la aprobación para su uso en adolescentes de su vacuna contra la mpox, la única aprobada por las autoridades competentes en Europa y Estados Unidos.
(Además: Elecciones 2025: Esta es la lista de candidatos a la Asamblea del PSC )
"Los resultados provisionales de estudios clínicos no muestran una respuesta inmune inferior de las vacunas en adolescentes y ofrecen perfiles de seguridad similares en comparación con los adultos, lo que respalda una extensión de la autorización actual en Europa más allá de 2024", afirmó la empresa en un comunicado.
Bavarian Nordic ha recordado que, aunque actualmente su uso sólo está indicado para mayores de 18 años, la vacuna ya recibió una autorización en caso de emergencia por la FDA durante la epidemia mundial de mpox en 2022 para aplicarla a personas de 12 a 17 años.
Para leer EXPRESO sin restricciones, SUSCRÍBETE AQUI